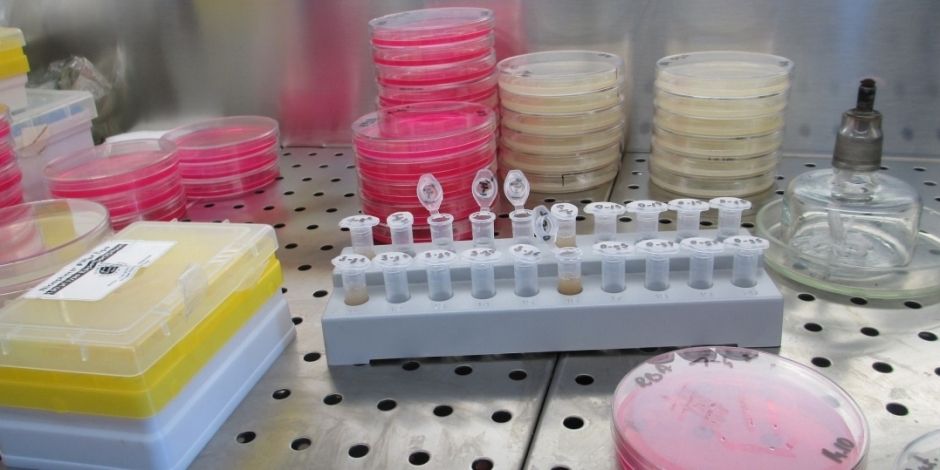

AB: Gesundheitsaktien - Wachstum jenseits der Pharmagiganten
Ein Gesundheitsportfolio muss nicht von Arzneimittelherstellern dominiert werden. Aktienanleger können Innovation und Wachstum auch anderswo finden.
08.11.2024 | 12:10 Uhr
Pharmaunternehmen stehen oft im Rampenlicht des Gesundheitssektors. Von COVID-Impfstoffen bis zu Gewichtabnahmepillen – bahnbrechende Pharmazeutika zielen darauf ab, die Leiden der Menschheit zu heilen und die Lebensqualität zu verbessern. Anleger sind oft begeistert vom Potenzial eines Blockbuster-Medikaments, das eine unheilbare Krankheit ausrotten soll – und ihnen einen ordentlichen Gewinn bescheren soll.
Da große Pharmaunternehmen zu den Schwergewichten im Gesundheitswesen gehören, dominieren sie oft die Sektorpositionen in einem globalen Aktienportfolio oder einer eigenständigen Allokation. Eine zu starke Konzentration auf die Pharmaindustrie könnte jedoch das Potenzial eines Portfolios einschränken. Unternehmen, die Diagnostika, Technologien und Geräte zur Lösung der drängendsten medizinischen Probleme der Welt herstellen, sind für den Fortschritt im Gesundheitssektor immer wichtiger geworden.
Die Veränderungen der Gesundheits-Aktienindizes in den letzten zwei Jahrzehnten spiegeln diese Verlagerung wider. Die Gewichtung von Pharmaunternehmen im MSCI World Health Care Index ist von 82 % im Jahr 2000 auf heute 43 % gesunken (Abbildung).

Diagnostik und biowissenschaftliche Instrumente und Dienstleistungen – Diese Bereiche sind für medizinische Prozesse ebenso wichtig wie die Behandlung selbst. Modernste Tests und bildgebende Verfahren können Medizinern helfen, Krankheiten in einem viel früheren Stadium zu erkennen, wodurch sich die Wirksamkeit der Behandlung und die Heilungschancen verbessern. Und die Sequenzierung des menschlichen Genoms wird weitere potenzielle neue Medikamente hervorbringen und dazu beitragen, Krankheiten früher zu erkennen.
Die Waters Corporation stellt Analysegeräte für die wissenschaftliche Forschung in der Arzneimittelentwicklung und in Produktionsprozessen her. In der stark regulierten Pharmaindustrie hat der gute Ruf des Unternehmens die Kundentreue aufrechterhalten und wiederkehrende Einnahmequellen generiert, die seine Wettbewerbsvorteile stärken. In den USA befindet sich auch das Unternehmen IDEXX Laboratories, das sich auf Tierdiagnostik spezialisiert hat, wie z. B. präzise, interne Laborgeräte, die Tierärzten innerhalb von 10 Minuten Ergebnisse liefern.
In der biotechnologischen Forschung und Entwicklung ermöglichen innovative Verfahren zur Arzneimittelentwicklung neue Behandlungen, die selbst bei relativ seltenen Erkrankungen profitabel sein können. United Therapeutics stellt beispielsweise ein Medikament zur Behandlung einer relativ seltenen Erkrankung namens pulmonale arterielle Hypertonie her – Bluthochdruck in der Lungenarterie. Das Unternehmen hat auch wieder in sein Organtransplantationsgeschäft investiert und versucht, mithilfe der Technologie zur Genom-Editierung die Akzeptanz von Organtransplantaten tierischen Ursprungs zu erhöhen, die vom menschlichen Körper oft abgestoßen werden.
Technologie und Künstliche Intelligenz (KI) – Im Vergleich zu anderen Sektoren war das Gesundheitswesen technologisch bisher ein Nachzügler. Doch das ändert sich jetzt. Unternehmen, die neue Technologien erfolgreich einsetzen, können die Art und Weise, wie Pflege angeboten und erbracht wird, drastisch verändern – und sie sind in verschiedenen Bereichen des Sektors zu finden.
Künstliche Intelligenz wird von Unternehmen wie Veeva Systems aus den USA und dem irischen Unternehmen ICON in kommerziellen Anwendungen eingesetzt. In dem Maße, wie sich die KI-Fähigkeiten verbessern und in größerem Umfang für die Diagnose von Krankheiten eingesetzt werden, werden sich unserer Meinung nach Unternehmen, die Software als Dienstleistung für das Gesundheitswesen anbieten, einer größeren Nachfrage erfreuen. GE HealthCare, ein Unternehmen für medizinische Geräte, setzt KI in verschiedenen Produkten ein, um beispielsweise die Qualität und die Diagnosefähigkeit von medizinischen Bildgebungsgeräten zu verbessern, was zu besseren Behandlungsergebnissen für Patienten führen kann.
Ausrüstung und Zubehör — Von globalen Arzneimittelherstellern bis hin zu Ihrem Hausarzt – die Geräte und Anwendungen, die zur Bereitstellung von Gesundheitsprodukten und -dienstleistungen verwendet werden, ändern sich ständig. Innovative Geräte, die bei lebensrettenden Verfahren eingesetzt werden, können die Ergebnisse für Patienten verbessern.
Für Chirurgen vollzieht sich derzeit eine rasante technologische Revolution. Bei der heutigen Chirurgie kommen zunehmend Roboter zum Einsatz, die es Chirurgen ermöglichen, schwer zugängliche Stellen im Körper mit hochpräzisen, minimalinvasiven Schnitten zu erreichen, was zu weniger Komplikationen und schnelleren Genesungszeiten führt. Das US-amerikanische Unternehmen Intuitive Surgical stellt ein Roboter-Chirurgiesystem her, welches in US-Operationssälen weit verbreitet ist und auch außerhalb der USA an Beliebtheit gewinnt. Unserer Meinung nach bestehen in Europa, Japan und China erhebliche Wachstumschancen.
Drei Attribute definieren gesundes Wachstum
Obwohl jede Branche eine andere Dynamik aufweist, sind wir der Meinung, dass Anleger auf drei Attribute achten sollten, um attraktive Unternehmen des Gesundheitswesens im gesamten Sektor zu identifizieren (Abbildung).
Erstens sollten sie nach Produkten und Dienstleistungen Ausschau halten, die die Ergebnisse der Gesundheitsversorgung für Patienten verbessern. Zweitens werden Unternehmen, die den finanzschwachen Gesundheitssystemen helfen können, Kosten zu sparen, wahrscheinlich von einer starken Nachfrage profitieren. Drittens müssen Produkte, die die Ergebnisse verbessern und Kosten sparen, einen Gewinn für das Unternehmen erwirtschaften.

Unserer Ansicht nach sind Unternehmen, die diese drei Eigenschaften aufweisen, in einem günstigen Umfeld tätig. Das bildet die Grundlage dafür, dass Unternehmen Cashflows gewinnbringend reinvestieren können, was im Laufe der Zeit zu einem beständigen Gewinnwachstum beiträgt. Wir sind der Meinung, dass sich Aktienanleger bei der Auswahl von Gesundheitsaktien stets auf die Geschäftsgrundlagen konzentrieren sollten, anstatt zu versuchen, den wissenschaftlichen Erfolg vorherzusagen, was äußerst schwierig ist.
Sicherlich sollten Pharmaunternehmen, die die Kriterien eines intakten Umfelds erfüllen, in einer diversifizierten Allokation von Gesundheitsaktien enthalten sein. Doch anstatt Arzneimittelhersteller als Anker eines Gesundheitsportfolios zu betrachten, sollte der Ausgangspunkt die Suche nach qualitativ hochwertigen Geschäftsmodellen sein – wo auch immer sie im sich entwickelnden Spektrum medizinischer Produkte und Dienstleistungen zu finden sind.
Die in diesem Dokument zum Ausdruck gebrachte Meinungen stellen keine Recherchen, Anlageberatungen oder Handelsempfehlungen dar und spiegeln nicht notwendigerweise die Ansichten aller Portfoliomanagementteams bei AB wider. Die Einschätzungen können sich im Laufe der Zeit ändern.
MSCI übernimmt keine ausdrückliche oder stillschweigende Gewährleistung oder Verantwortung und kann für die hierin enthaltenen MSCI-Daten nicht haftbar gemacht werden.
Die MSCI-Daten dürfen nicht weitergegeben oder als Grundlage für andere Indizes, Wertpapiere oder Finanzprodukte genutzt werden. Dieser Bericht wurde von MSCI nicht genehmigt, überprüft oder selbst erstellt.
Verweise auf bestimmte behandelte Wertpapiere dienen nur zur Veranschaulichung und sollten nicht als Empfehlungen von AllianceBernstein L.P. angesehen werden. Es sollte nicht davon ausgegangen werden, dass Investitionen in die genannten Wertpapiere notwendigerweise profitabel waren oder sein werden.
Dies ist eine Marketing-Anzeige. Diese Informationen werden von AllianceBernstein (Luxemburg) S.à.r.l. gegeben, einer im Luxemburger Handels- und Unternehmensregister (R.C.S.) eingetragenen Gesellschaft mit beschränkter Haftung. Luxemburg B 34 305, 2-4, rue Eugène Ruppert, L-2453 Luxemburg. AllianceBernstein S.à.r.l. unterliegt der Aufsicht durch die Aufsichtskommission des Finanzsektors (CSSF). Dies wird nur zu Informationszwecken angegeben und ist nicht als Anlageberatung oder Aufforderung zum Kauf eines Wertpapiers oder einer sonstigen Anlage zu verstehen. Die hier geäußerten Ansichten und Meinungen basieren auf unseren internen Prognosen und geben keine zuverlässigen Hinweise auf die zukünftige Marktperformance. Die Fondsanlagen können an Wert gewinnen und verlieren, und es kann vorkommen, dass die Anleger nicht den vollen angelegten Betrag zurückerhalten. Die Performances der Vergangenheit bieten keine Gewähr für zukünftige Ergebnisse.
Diese Informationen richten sich lediglich an Privatpersonen und sind nicht für die Öffentlichkeit bestimmt.
© 2024 AllianceBernstein L.P.

Diesen Beitrag teilen: